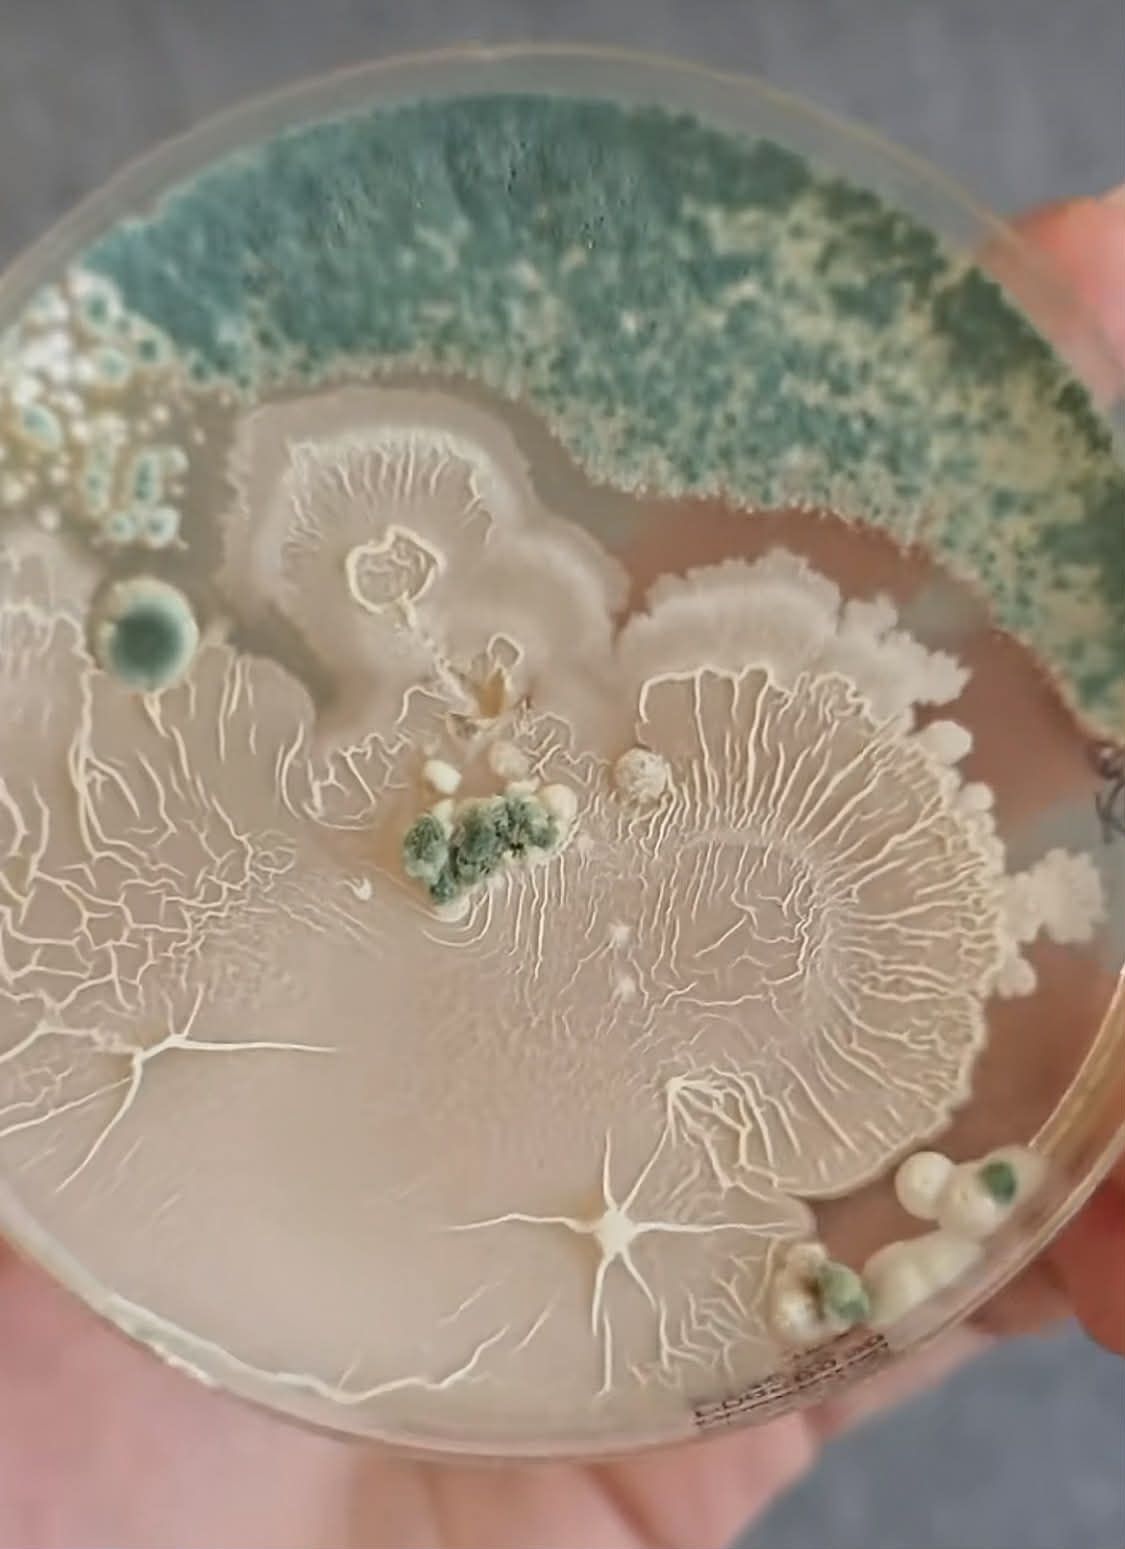
penész

Végzetes tragédia történt a bungee jumpingon: ezért halt meg egy 21 éves nő
Megszólalt a polgármester.
Itt állíthatja be, hogy a Google keresőben elsők között legyen a MetropolAz eredmény megdöbbentő. A nagy penészes kenyérteszt alapján te is átgondolod majd az étkezési szokásaidat.
Gyuris Rita növényorvos egy szelet penészes kenyérrel szemléltette, hogy miért veszélyes az a berögződés, hogy sokan egyszerűen csak kicsípik a penészfoltot és megeszik azt a részt, ahol szemmel láthatólag még nincs penész. Hiába tűnik menthetőnek az étel, a felszín alatt a gombafonalak már átszőttek mindent.
A TikTok kedvenc növényorvosa, Rita csipesszel kicsípte a penészdarabot a kenyérből és speciális táptalajra, úgynevezett agarlemezre helyezte, majd fertőtlenítette a csipeszt és a kenyér nem penészes részéből is kivett egy darabot és egy másik agarlemezre helyezte. Két nap után összehasonlította a mintákat.
A penészes kenyérrészről elkezdett növekedni a penész. Az idő előrehaladtával még tovább szaporodnak és növekednek, ezek a telepek
– állapította meg.

A másik mintán – amit a kenyér széléből vettünk, ahol ránézésre nem volt penész – is jelen van a zöldes színű penészgomba. Összetett mikrobiális tenyészet látható. Ezek lehetnek olyan baktériumok, vagy élesztő gombák, melyek a penésszel együtt kolonizálják az adott ételt
– mondta a növényorvos.
Amennyiben már penészt látunk bármilyen élelmiszeren – kenyéren, citromon, péksüteményen és még sorolhatnánk... – azt nem szabad megenni.
Megromlott, vagy romlásban lévő ételen rengeteg mikroorganizmus található; baktériumok és gombák vegyesen. Becsapós, mert ezeket általában szabad szemmel nem láthatjuk. Amikor a penészt, a zöldes és feketés pöttyöket észrevesszük a kenyéren és kicsípjük, attól még a gombának a micéliumai, tehát a gombafonalak már átszőtték szinte az egész kenyeret. Általában már akkor láthatjuk a penészt, amikor az már spórákat termel, hogy tovább tudjon szaporodni
– mondta a növényorvos, hangsúlyozva: a penészes ételeket nem szabad megenni, mert mikotoxinokat, méreganyagokat termelhet a gomba.

Megszólalt a polgármester.

A Kulacs étterem, amit sosem felejtünk!

A férfi teljesen összetört, hogy ő az oka.
Nem akar lemaradni a Metropol cikkeiről? Adja meg a nevét és az e-mail címét, és mi hetente három alkalommal elküldjük Önnek a legjobb írásokat!
Feliratkozom a hírlevélrePortfóliónk minőségi tartalmat jelent minden olvasó számára. Egyedülálló elérést, országos lefedettséget és változatos megjelenési lehetőséget biztosít. Folyamatosan keressük az új irányokat és fejlődési lehetőségeket. Ez jövőnk záloga.